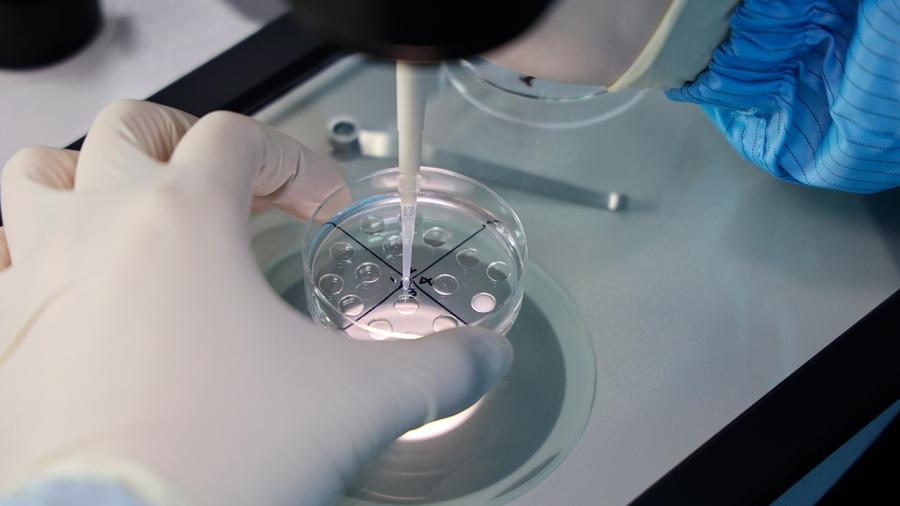

Мир
ИИ уже скоро может оставить без работы миллионы юристов по всему миру
USD 74,6200 EUR 85,4847
Главная » НОВОСТИ » Общество » В США родился ребенок из эмбриона, замороженного более 30 лет назад
31.07.2025 11:56
В США ребенок родился из эмбриона, который хранился с 1994 года. Об этом сообщает научный журнал MIT Technology Review.
Супружеская пара из Огайо "усыновила" эмбрион у женщины, которая в 1994 году прошла процедуру ЭКО, тогда врачам удалось создать четыре эмбриона. Один из них был использован для искусственного оплодотворения, в результате которого родилась девочка. Оставшиеся три эмбриона женщина планировала заморозить и сохранить для себя, однако позже решила пожертвовать эмбрионы специальному христианскому агентству по хранению и "усыновлению" клеток, сообщает журнал.
"Усыновление" эмбриона является способом сохранения клеток, при котором донор и "приемные" родители могут решить, кому передать эмбрион или от кого он будет передан. Чаще всего подобную возможность предоставляют специальные христианские агентства, которые верят, что эмбрион в моральном плане равен рожденному ребенку.
Все права защищены. При перепечатке ссылка на сайт ИА "Грозный-информ" обязательна.
Нашли ошибку в тексте? Выделите ее мышкой и нажмите: Ctrl+Enter
Поделиться: